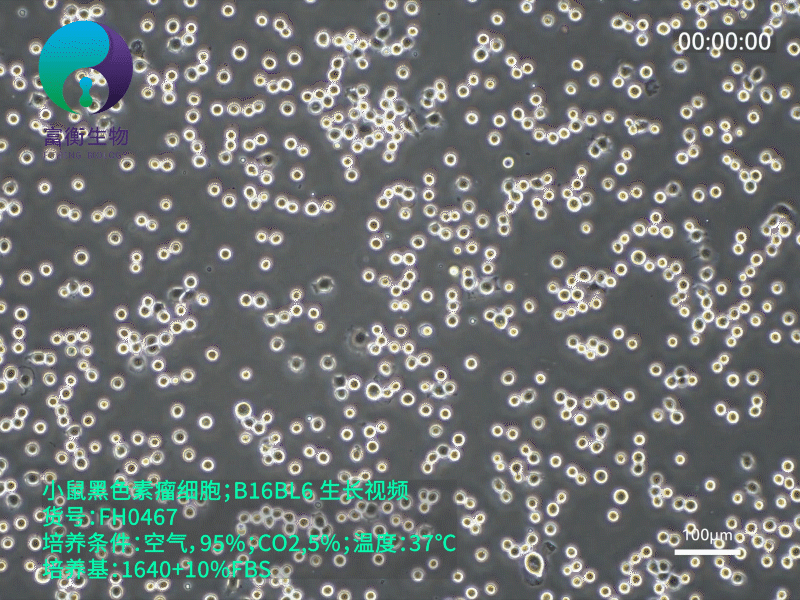
技术资料图片1

5 年
手机商铺
入驻年限:5 年
刘胜富
上海 闵行区
抗体、ELISA 试剂盒、细胞库 / 细胞培养、论文服务、试剂、实验室仪器 / 设备、技术服务、耗材
代理商 经销商 生产厂商 科研机构
技术资料/正文
103 人阅读发布时间:2025-05-16 09:27
小鼠黑色素瘤细胞 B16BL6 的故事始于半个多世纪前。20 世纪 50 年代,科研人员在 C57BL/6 品系小鼠体内发现了自发性恶性黑色素瘤,随后通过细胞分离与纯化技术,成功建立了 B16BL6 细胞系。C57BL/6 小鼠作为经典的近交系实验动物,遗传背景高度均一,使得 B16BL6 细胞在不同实验室间的实验结果具备良好的重复性,这一特性为肿瘤学基础研究与药物开发搭建了坚实的模型基础。
B16BL6 细胞的生物学特征极具辨识度。从形态学观察,细胞呈上皮样生长模式,在培养瓶底部贴壁时,会伸展为多边形或梭形,随着细胞密度增加,还会呈现出漩涡状或放射状的排列特征。在功能层面,其高致瘤性堪称 “肿瘤模型界的标杆”:当将 1×10⁶个 B16BL6 细胞皮下接种至同系小鼠,仅需 7 - 10 天就能形成直径超 5mm 的实体瘤;更值得关注的是,该细胞具有天然的肺转移倾向,通过尾静脉注射后,可在肺部形成密集的转移灶,完美复刻了人类黑色素瘤晚期的侵袭路径。此外,细胞内高表达的酪氨酸酶,驱动着黑色素的持续合成,使得 B16BL6 细胞呈现出独特的深褐色,科研人员可借助这一可视化特征,快速评估细胞活性、增殖状态以及药物干预效果。
在实验室培养环节,B16BL6 细胞既 “顽强” 又 “挑剔”。其基础培养基选用高糖型 DMEM,需额外添加 10% 优质胎牛血清,以补充细胞生长所需的生长因子与营养物质。培养环境需严格控制在 37℃、5% 二氧化碳的恒温恒湿培养箱中,二氧化碳不仅能维持培养液 pH 在 7.2 - 7.4 的适宜范围,还参与细胞的代谢调控。在传代操作中,需把握 “适度原则”:当细胞融合度达到 80% - 90% 时,采用 0.25% 胰蛋白酶消化,轻柔吹打收集细胞,避免过度消化损伤细胞膜;若接种密度过高,细胞易因接触抑制而停止增殖,过低则会导致细胞状态变差。对于长期保存,需将细胞重悬于含 10% DMSO、20% 胎牛血清的冻存液中,使用程序降温盒以每分钟 1℃的速率降至 - 80℃,再转移至液氮罐,如此操作可确保细胞在复苏后仍保持 90% 以上的存活率。深入掌握这些培养要点,能让 B16BL6 细胞持续为肿瘤机制探索与创新疗法研发贡献力量。